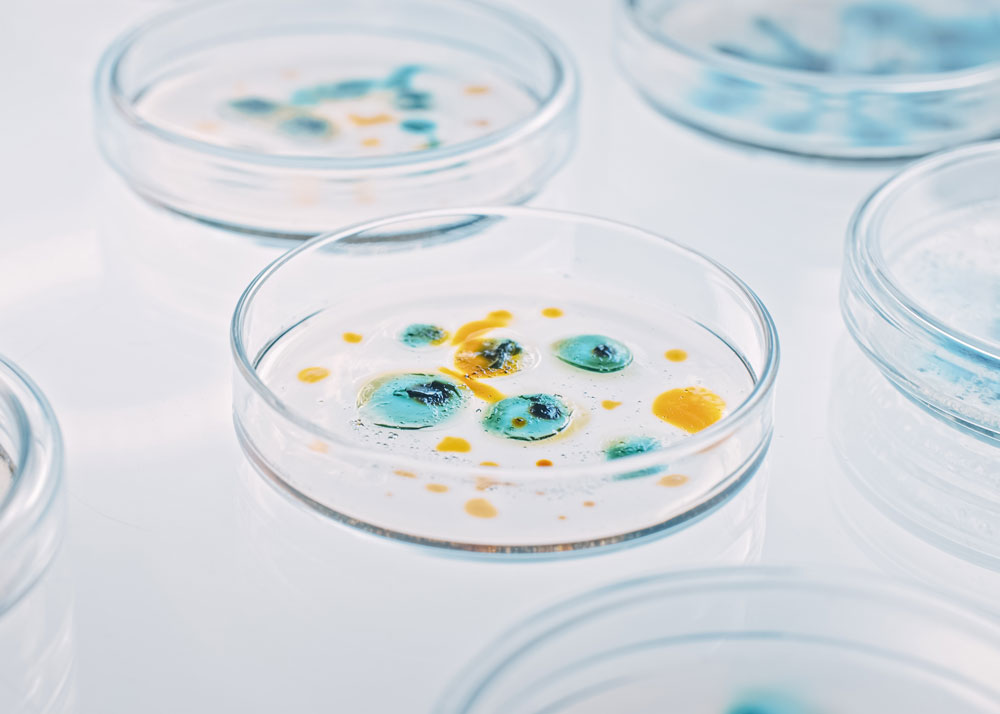

Sanger Sequencing and Fragment Analysis
Accessories and Reagents
Fragment Analysis
Sanger Sequencing

Molecular Cloning
Cloning & Sub Cloning
Competent Cells
Culture Plates
DNA Ladder
Nucleic Acid Electrophoresis
PCR Kits
PCR Polymerases
PCR Reagents
RT-PCR Kits

PCR
PCR Kits
PCR Primer Sets
PCR Reagents
Real-Time PCR Kits

Next-Generation Sequencing
NGS Enzyme & Amplification Technology
NGS Library Preparation Kit
NGS Library Quantification Kit
NGS Miscellaneous
NGS Reagent Module Kit

Biochemical Reagents
Biochemical Reagents

Antibodies
Primary Antibodies
Secondary Antibodies
Flow Cytometry Antibodies
Antibody Pairs
Isotype Controls

Molecular Biology
PCR Kits
Superparamagnetic Beads
Quantum Dot Kit
Fluorescent Microspheres
Small Molecules
Extraction Kits

ELISA Kits
Sandwich ELISA
Competitive ELISA / EIA
Indirect ELISA
Phosphorylation ELISA
Cell-Based ELISA
Immuno-PCR Assays
Transcription Factor ELISA
Bridging ELISA
Ligand Binding Assays
ELISA Buffers and Reagents

Protein Purification
Chaperon Proteins and Disulfide Bond Isomerase
Protease
Protein A
Protein Array Blocking Reagent
Protein G
Protein Purification Resins
Protein Purification Solutions
SDS-PAGE Gel Products

Enzymes
Chaperon Proteins and Disulfide Bond Isomerase
DNA Repair Proteins
DNA/RNA Ligases
Helicase
Kinases
Luciferase
Lysozyme
Mesophilic DNA Polymerases
Nucleases
pAGO Nucleases
Phosphatases and Sulfurylases
Protease
Restriction Endonucleases
Reverse Transcriptase and RNA Polymerases
RNases
Single-Stranded DNA Binding Proteins
Thermophilic DNA Polymerases

Nucleic Acid Purification
Agarose Beads
CE-Sequencing Clean-Up
DNA Extraction
Gel Extraction
Magnetic Beads
Magnetic Particle Separation Tools
Next-Generation Sequencing Size Selection
PCR Clean Up
Plasmid Prep Kit

Recombinant Proteins
ApoA1
Biotin-binding Proteins
Enzymes
Human Nicotinamide Phosphoribosyltransferase
Recombinant BTX Protein
NGF

FastSep™ IMAC
FastSep™ Protein Purification Cartridges
FastSep™ Protein Purification Resins
Prepacked Columns
Gene Editing
CRISPR/Cas12a System
CRISPR/Cas12a2 System
CRISPR/Cas13 System
CRISPR/Cas9 On-target Detection
CRISPR/Cas9 System
pAGO System

Multiplex Arrays
Proteome Profiling Arrays
Antibody Arrays
Post-Translational Modification Arrays
Cytometric Bead Arrays
Protein Arrays
Peptide Epitope Mapping Arrays